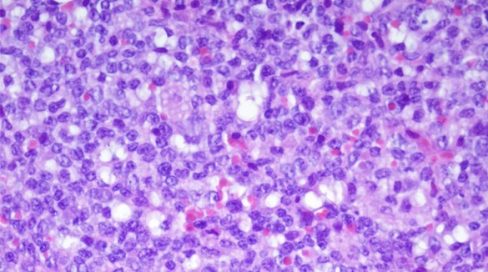

NOTICIAS DE MAYO
Luz verde al fármaco que mantiene en ‘stand by’ al mieloma múltiple https://t.co/crPnyKglkN Descifrada la estructura de una enzima clave en el envejecimiento y el cáncer https://t.co/Tgq9GLmwmw Cáncer hematológico e inmunoterapia, el reto de los fármacos que vienen https://t.co/mIdMYoXmN2 TERRAs, los RNAs teloméricos, son importantes reguladores epigenéticos https://t.co/BbhSZjQN38 Una nueva vacuna contra el cáncer arroja…
Detalles